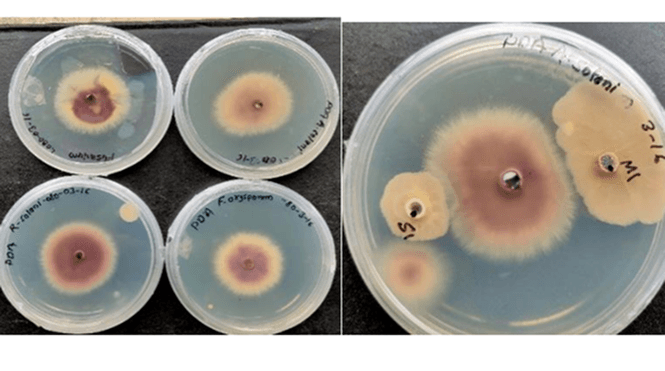
Hyper-tolerant As-resistant Bacillus species from agricultural soil

Research
Explore my recent projects.
Hyper-tolerant As-resistant Bacillus species from agricultural soil
Two strains - B. cereus and B. weidmanii showed plant growth-promoting traits (auxin production, phosphate and zinc solubilization, nitrogen fixation, biofilm formation, and hydrogen cyanide (HCN) production), strong biocontrol activity, and yielded significant improvements in shoot and root length, leaf area, chlorophyll content, and soluble protein levels even in arsenic-contaminated soils.
Learn more →